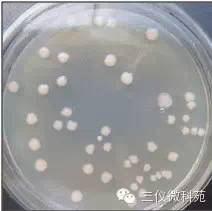

丁酸梭菌(Clostridium butyricum)又名酪酸梭菌、丁酸梭状芽孢杆菌,是芽孢杆菌科、梭菌属的一种产丁酸、革兰氏阳性厌氧细菌。1933年日本千叶医学院Miyairy博士首次从粪便中分离出了丁酸梭菌,随后发现其培养物中含有少量的脂肪酸,可抑制肠道中有害菌生长并促进有益菌的生长。丁酸梭菌被广泛用作人肠炎治疗药物、食品添加剂、兽药和饲料添加剂。在韩国和日本,丁酸梭菌早已被用作畜禽饲料添加剂,中国于2009年批准丁酸梭菌为新饲料添加剂。2016年江苏三仪生物产业集团制定的丁酸梭菌及新型复合酶制剂企业质量标准通过验收。验收通过,标志着江苏三仪生物产业集团具备了功能性微生态制剂—丁酸梭菌为主的单一型及混合型饲料添加剂生产资质,此项资质的获得填补了国内高浓度丁酸梭菌微生态制剂的空白。

1 实验材料
共培养用液体培养基;LB培养基
2 实验方法
2.1 丁酸梭菌对霍乱沙门氏菌的抑制作用
①霍乱沙门氏菌种子培养
取平板活化好的菌种转接到LB液体三角瓶中,装液量25 mL/100 mL, 37℃,150 r/min培养12-24h,取培养菌液测活菌数和pH值。
②丁酸梭菌单独培养
取丁酸梭菌菌粉0.1 g接种到装量为25 mL/30mL的细菌培养瓶中,置于37℃静止恒温培养24 h左右。(可按此比例扩大培养体积,最低比例为0.1 g:25 mL)
③丁酸梭菌和霍乱沙门氏菌混合培养
活化好的丁酸梭菌培养液1 mL接种到装液量为20 mL/30mL的细菌培养瓶中,再把培养好的霍乱沙门氏菌菌液1 mL同时接入该共培养液中, 37℃恒温静止培养。对照组为向同样的共培养液体培养基中(装液量为20 mL/30 mL)接种霍乱沙门氏菌菌液1 mL,37℃恒温静止培养。分别在16和24 h测pH值及沙门氏菌活菌数。
④计数采用平板涂布法
选择2~3个适宜梯度稀释液,吸取100 μL涂布平板,倒置于严格厌氧培养箱或严格厌氧培养袋中,37℃培养18~36 h后计数。每个梯度做两个平行,每个平板的菌落数在30~300范围内有效。
2.2 丁酸梭菌对肠出血性大肠杆菌、魏氏梭菌的抑制作用
实验方法同上,魏氏梭菌种子液为严格厌氧,应采用共培养液体培养基。
3 实验结果
3.1 对霍乱沙门氏菌的抑制结果
丁酸梭菌对霍乱沙门氏菌表现出非常强的抑制作用,24h活菌数从单独培养时2.0×108CFU/mL减少到1.2×103CFU/mL。
3.2 对肠出血性大肠杆菌的抑制结果
混合培养16h,肠出血性大肠杆菌活菌数从单独培养时3.5×108CFU/mL减少到7×106 CFU/mL,24 h活菌数减少到0.4×106 CFU/mL,pH从6.8下降至4.6,呈现良好抑制作用。
3.3 对魏氏梭菌的抑制作用
混合培养后,魏氏梭菌活菌数从单独培养时的1×108 CFU/mL减少到1×105CFU/mL, pH值从6.8下降到4.5,表现出良好的抑制作用。
4 小结
(1)丁酸梭菌为严格厌氧菌,产氢气。液体培养基中加入厌氧指示剂,粉红色表明培养基上层有氧;

培养一段时候后液体表面有气泡,为正常现象。

(2)丁酸梭菌平板形态如下。
(3)丁酸梭菌对霍乱沙门氏菌、肠出血性大肠杆菌和魏氏梭菌均有显著的抑制作用,可将肠出血性大肠杆菌和魏氏梭菌细菌含量控制在发病浓度之下,防止发病。尤其是对霍乱沙门氏菌抑制作用更强,可以达到净化霍乱沙门氏菌的作用。
5、结论
益生菌可以使糖类发酵形成有机酸和短链脂肪酸,这些酸能维持酸性环境,降低肠道的 pH 值,防止病原菌及腐败菌在肠道内异常增殖,减少肠毒素。此外,益生菌还可产生醇、过氧化氢等物质,合成溶菌酶、细菌素和抗菌肽等抗菌物质,达到对致病菌的抑制作用。故丁酸梭菌可以有效抑制沙门氏菌、大肠杆菌、魏氏梭菌的生长。







 本文介绍了丁酸梭菌的特性及其在抑制霍乱沙门氏菌、肠出血性大肠杆菌和魏氏梭菌方面的显著效果。实验结果显示,丁酸梭菌能有效降低这些有害菌的活菌数,为潜在的肠道健康调节剂。
本文介绍了丁酸梭菌的特性及其在抑制霍乱沙门氏菌、肠出血性大肠杆菌和魏氏梭菌方面的显著效果。实验结果显示,丁酸梭菌能有效降低这些有害菌的活菌数,为潜在的肠道健康调节剂。

















 被折叠的 条评论
为什么被折叠?
被折叠的 条评论
为什么被折叠?








